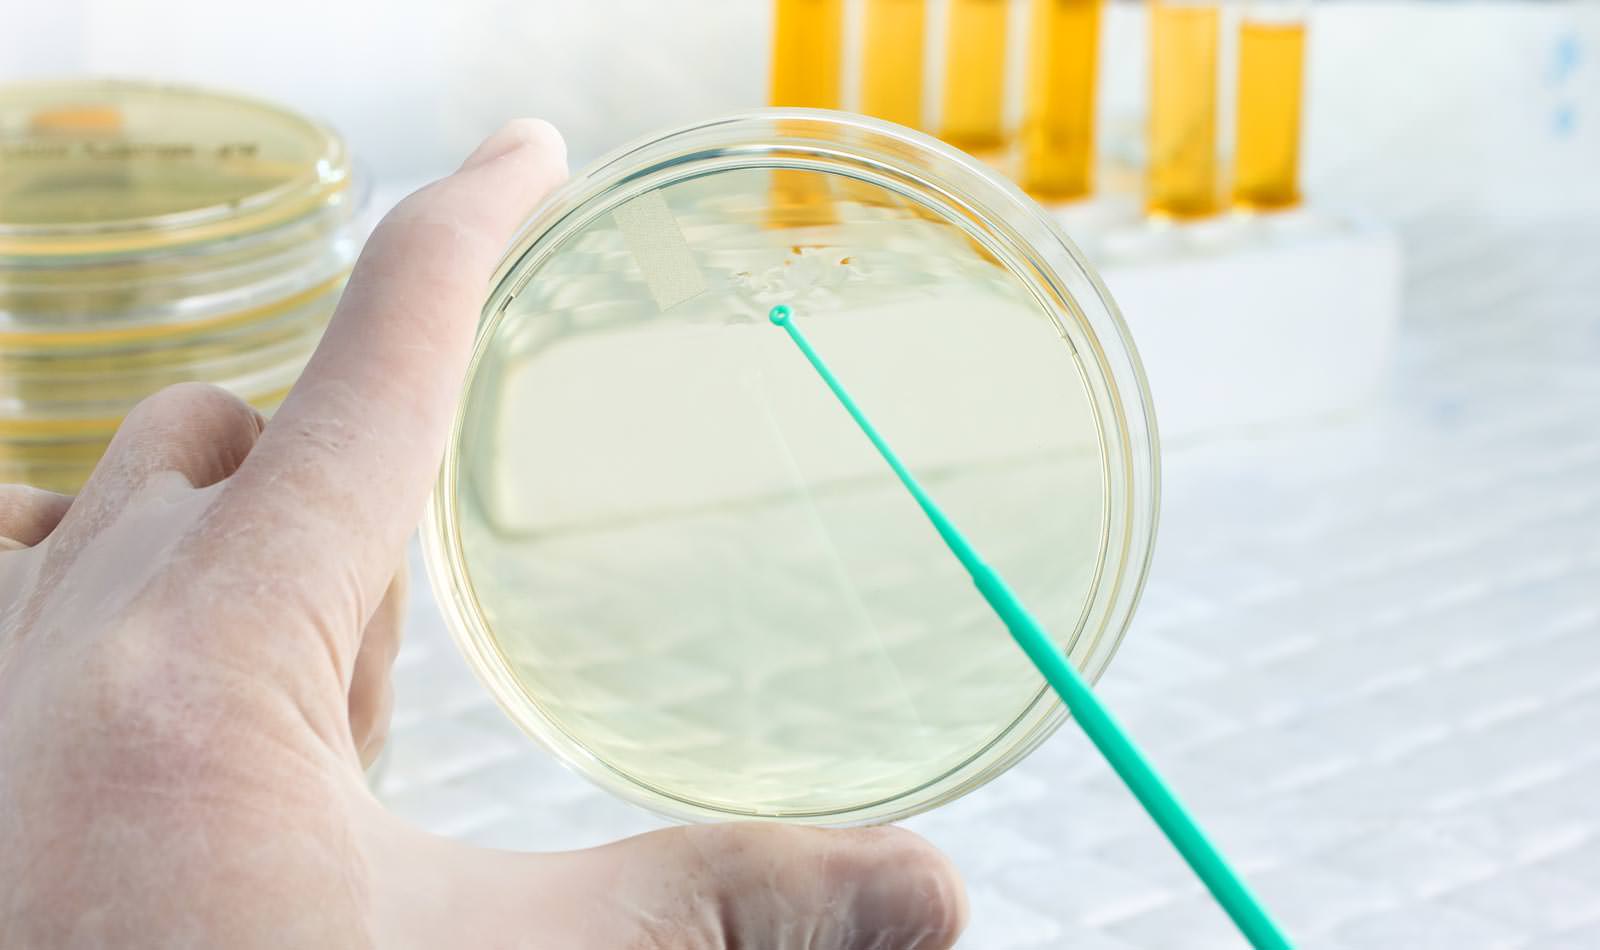

Μικροβιολόγος στο σπίτι
ΜΙΚΡΟΒΙΟΛΟΓΟΣ ΚΑΤ' ΟΙΚΟΝ
✔ SOS Νοσηλευτής άμεσα στο σπίτι σας
✔ Μεταφορά δείγματος σε διαγνωστικό εργαστήριο
✔ Άμεσα αποτελέσματα
✔ Έλεγχος πηκτικότητας, ορμονολογικός, αντισωμάτων κλπ.
✔ Διερεύνηση των επιπλέον αναγκών του ασθενούς και συνεργασία με όλες τις SOS ειδικότητες
✔ Για ασθενείς με αδυναμία μετακίνησης (έγκυοι, ηλικιωμένοι, ΑΜΕΑ κλπ)
Ο μικροβιολόγος είναι ειδικευμένος ιατρός που ασχολείται με την διάγνωση, την πρόληψη και τη θεραπεία ασθενειών που οφείλονται σε μικροοργανισμούς.
Οι SOS ΙΑΤΡΟΙ συνεργάζονται με τα πιο σύγχρονα μικροβιολογικά διαγνωστικά εργαστήρια, ώστε τα έγκυρα αποτελέσματα των διαγνωστικών σας εξετάσεων να εκδίδονται αμέσως και να σας παραδίδονται στο σπίτι σας.
ΣΥΝΕΡΓΑΣΙΑ ΜΙΚΡΟΒΙΟΛΟΓΟΥ- ΝΟΣΗΛΕΥΤΗ- ΘΕΡΑΠΟΝΤΑ ΙΑΤΡΟΥ
- Ο θεράπων ιατρός παραγγέλνει τις διαγνωστικές εξετάσεις που χρειάζεται
- SOS νοσηλευτής έρχεται στο σπίτι σας αμέσως ή μετά από ραντεβού σε ώρες και ημέρες που ορίζετε εσείς
- Ο νοσηλευτής λαμβάνει βιολογικά υγρά και τα μεταφέρει στο διαγνωστικό εργαστήριο
- Οι διαγνωστικές μικροβιολογικές εξετάσεις πραγματοποιούνται με τα πιο σύγχρονα μέσα
- Εξασφαλίζεται άμεση έκδοση των αποτελεσμάτων
- Τα αποτελέσματα των εξετάσεων παραδίδονται στο σπίτι του ασθενούς αμέσως, ακόμα και μέσα στην ίδια ημέρα
- Ο θεράπων γιατρός ενημερώνεται για τα αποτελέσματα των εξετάσεων ηλεκτρονικά
ΤΟ ΜΙΚΡΟΒΙΟΛΟΓΙΚΟ ΕΡΓΑΣΤΗΡΙΟ ΠΡΑΓΜΑΤΟΠΟΙΕΙ ΟΛΕΣ ΤΙΣ ΔΙΑΓΝΩΣΤΙΚΕΣ ΕΞΕΤΑΣΕΙΣ
- Αιματολογικό – έλεγχος πηκτικότητας
- Ανοσολογικός – ορμονολογικός έλεγχος
- Έλεγχος ηπατίτιδας , HIV
- Έλεγχος αυτοάνοσων νοσημάτων
- Έλεγχος αντισωμάτων
- Βιοχημικός έλεγχος – καρκινικοί δείκτες
- Βιοχημικός έλεγχος – εξετάσεις θυρεοειδούς
- Λιπιδαιμικός έλεγχος
- Ένζυμα και καρδιακοί δείκτες
- Ηπατικοί δείκτες
- Ηλεκτρολύτες
- Λευκώματα
- Εξετάσεις αναιμίας
- Βιοχημικός έλεγχος
- Καλλιέργειες (καλλιέργεια ούρων, αίματος, σπέρματος, κοπράνων κ.α.)
- Πυρηνική ιατρική
- Κυτταρολογικός έλεγχος
- Έλεγχος για γενετικές ανωμαλίες